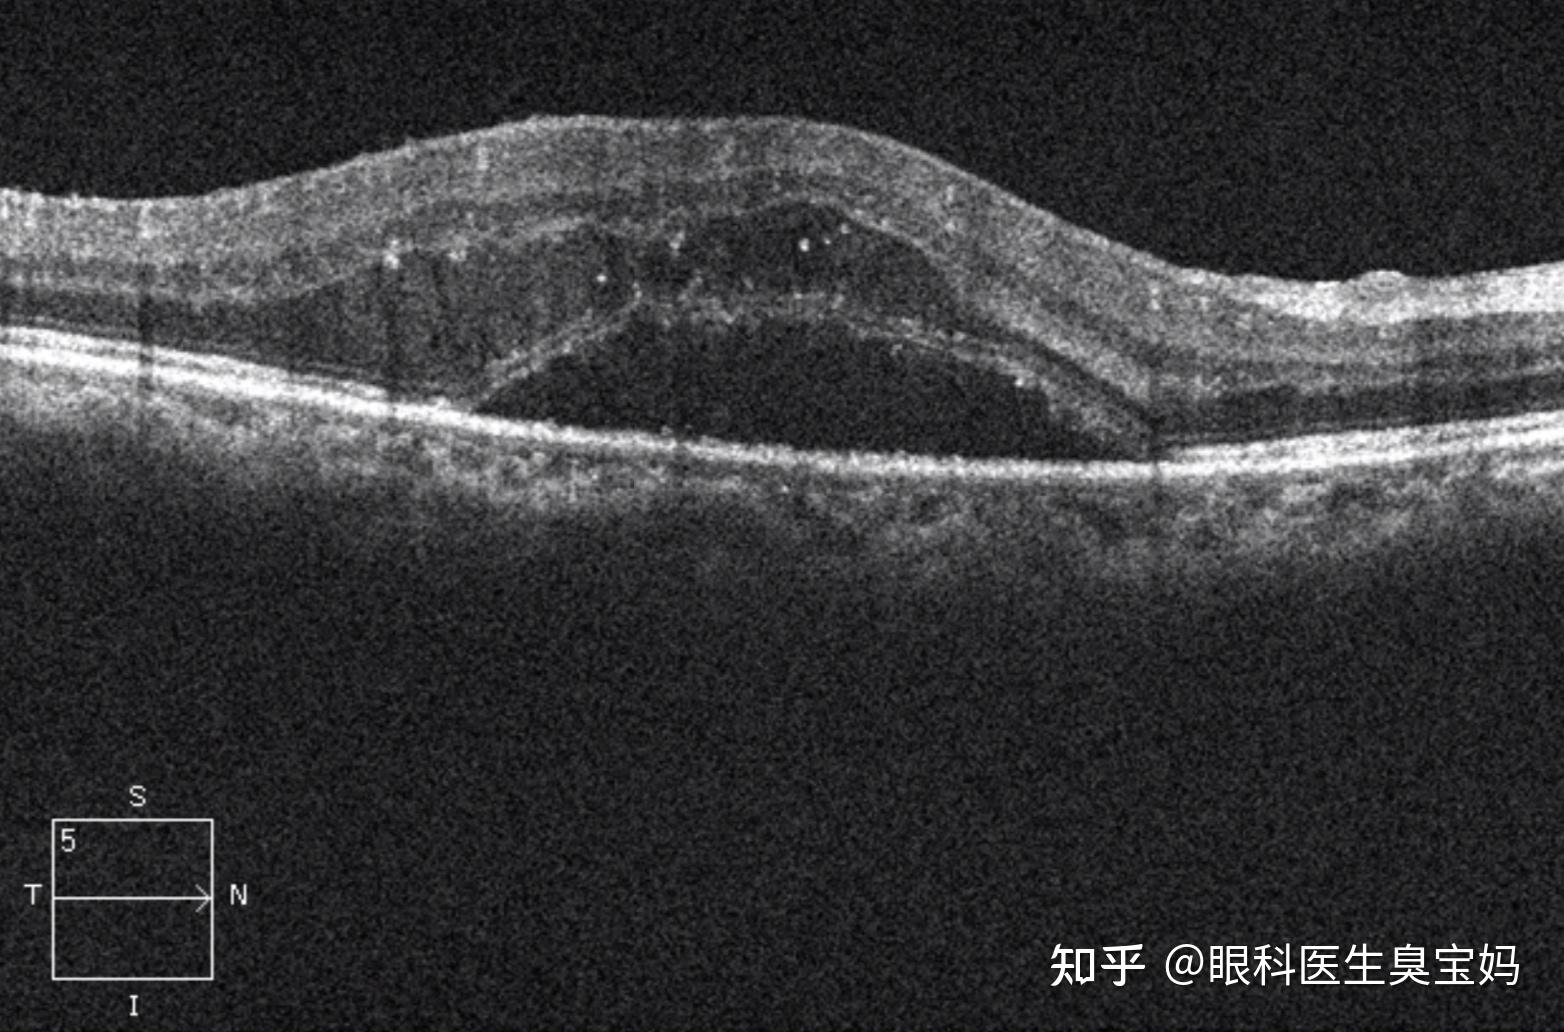
oct:可快速无创检查黄斑区有无水肿及水肿的厚度,范围.

黄斑水肿oct图片

临床综述:oct眼中的黄斑水肿
图片尺寸554x244
黄斑水肿(me)_黄斑水肿_介绍_症状表现_检查 - 好大夫在线
图片尺寸2675x3080
眼底黄斑水肿的oct表现
图片尺寸640x329
眼部oct(左图:治疗前,右图:治疗后18天,可见视网膜水肿明显好转)
图片尺寸597x597
黄斑水肿
图片尺寸836x595赵立全博士坐诊,针对糖尿病视网膜病变,黄斑水肿,高血压眼底出血,玻璃
图片尺寸786x813
临床综述:oct眼中的黄斑水肿
图片尺寸554x271
【眼底病讨论】一例不明原因双眼黄斑水肿患者
图片尺寸2810x2430
图 1 crvo合并黄斑水肿
图片尺寸1040x596
黄斑囊样水肿
图片尺寸888x370
糖尿病黄斑水肿有这三种 治疗方式
图片尺寸744x540
oct)可以提供黄斑的切面的微观结构分析,是临床诊断糖尿病性黄斑水肿
图片尺寸797x302
临床综述:oct眼中的黄斑水肿
图片尺寸554x760
黄斑疾病系列之三黄斑水肿 - 好大夫在线
图片尺寸493x335
一例年轻患者特殊的黄斑水肿. - 好大夫在线
图片尺寸2733x3261
黄斑囊样水肿治疗前后oct图像对比
图片尺寸3648x2736![【病例讨论】分支静阻致黄斑水肿怎么办? [病例帖]](https://i.ecywang.com/upload/1/img1.baidu.com/it/u=1331486655,3319399062&fm=253&fmt=auto&app=138&f=JPEG?w=500&h=375)
【病例讨论】分支静阻致黄斑水肿怎么办? [病例帖]
图片尺寸2208x1656
【眼底病讨论】一例不明原因双眼黄斑水肿患者
图片尺寸813x705
视网膜下注射平衡盐溶液治疗难治性糖尿病黄斑水肿一例
图片尺寸1181x1949
oct:可快速无创检查黄斑区有无水肿及水肿的厚度,范围.
图片尺寸1564x1032
猜你喜欢:黄斑水肿OCT黄斑oct的正常图解黄斑区oct检查图解黄斑前膜oct图像黄斑水肿黄斑水肿oct图片解释黄斑变性oct图片轻微黄斑病变oct图片正常黄斑图片如何看眼底照相图黄斑囊样水肿oct图片黄斑水肿的图片黄斑水肿oct黄斑囊样水肿图片黄斑水肿的oct报告图黄斑水肿oct的详细图解正常眼底黄斑oct图片眼底黄斑oct图片解说正常黄斑oct图像眼底黄斑病变图片黄斑oct正常眼底oct图片黄斑oct正常结膜水肿图片水肿图片黄斑oct的详细图解黄斑囊样水肿正常人眼底oct图片中浆眼病oct图片黄斑前膜oct宋仁宗画像掖庭椒心碎图片绝望伤感西单1986年人肉包子金钥匙奖获奖名单穿西装图片草帽动漫学会尊重他人的图片小钱钱 兔子潘海利根狐狸头香水壁纸天行九歌鸟手绘插画















![【病例讨论】分支静阻致黄斑水肿怎么办? [病例帖]](https://img.dxycdn.com/upload/2010/10/01/29828394.jpg)